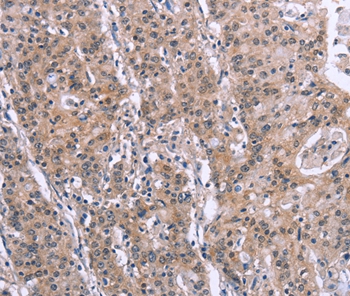

-
分类: 科研抗体货号: P42914别名: HIWI3应用: WB,IHC反应种属: Human,Mouse
-
分类: 科研抗体货号: P42912别名: A3D; ARP6; APOBEC3E; APOBEC3DE应用: WB,IHC反应种属: Human,Mouse
-
分类: 科研抗体货号: P42930别名: PAR2; RFT1; RBFVD; RFVT1; hRFT1; GPCR42; GPR172B应用: IHC反应种属: Human
-
分类: 科研抗体货号: P42910别名: ADAM-TS 17; ADAM-TS17; ADAMTS-17; ADAMTS17; ATS17; FLJ16363; FLJ32769应用: WB,IHC反应种属: Human,Mouse
-
分类: 科研抗体货号: P42947别名: PARP7; ARTD14; pART14应用: WB反应种属: Human,Mouse
-
分类: 科研抗体货号: P42929别名: Geph应用: IHC反应种属: Human,Mouse,Rat
-
分类: 科研抗体货号: P42908别名: SALPR; RLN3R1; RXFPR3; GPCR135应用: WB,IHC反应种属: Human,Mouse
-
分类: 科研抗体货号: P42946别名: SIP; Teap; p53DINP1; TP53DINP1; TP53INP1A; TP53INP1B应用: WB,IHC反应种属: Human
-
分类: 科研抗体货号: P42928别名: AL4; CT4.7; GAGE7B; GAGE-7B应用: WB,IHC反应种属: Human
-
分类: 科研抗体货号: P42906别名: TRP3应用: WB,IHC反应种属: Human

鄂公网安备42018502007531号
鄂公网安备42018502007531号

